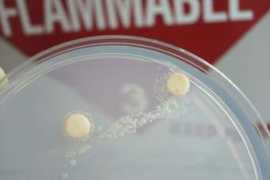
Hooshangi

First names for Hooshangi
- Iman Hooshangi 4
- Hamid Hooshangi 4
- Hadi Hooshangi 4
- Ebrahim Hooshangi 4
- Amir Hooshangi 4
- Omid Hooshangi 3
- Mohammad Hooshangi 3
- Alireza Hooshangi 3
- Zeinab Hooshangi 2
- Vahid Hooshangi 2
- Usef Hooshangi 2
- Siamak Hooshangi 2
- Shayan Hooshangi 2
- Shahriar Hooshangi 2
- Shahab Hooshangi 2
- Sara Hooshangi 2
- Sahar Hooshangi 2
- Saeed Hooshangi 2
- Sadegh Hooshangi 2
- Reza Hooshangi 2
- Ramin Hooshangi 2
- Peyman Hooshangi 2
- Payam Hooshangi 2
- Parisa Hooshangi 2
- Navid Hooshangi 2
- Mostafa Hooshangi 2
- Morteza Hooshangi 2
- Mohsen Hooshangi 2
- Milad Hooshangi 2
- Meysam Hooshangi 2
- Mehdi Hooshangi 2
- Mamad Hooshangi 2
- Mahsa Hooshangi 2
- Mahdi Hooshangi 2
- Irani Hooshangi 2
- Hossein Hooshangi 2
- Hosein Hooshangi 2
- Hooshang Hooshangi 2
- Hirbod Hooshangi 2
- Hesam Hooshangi 2
- Hengame Hooshangi 2
- Hemn Hooshangi 2
- Hatef Hooshangi 2
- Hasti Hooshangi 2
- Hasan Hooshangi 2
- Hamoon Hooshangi 2
- Hamed Hooshangi 2
- Haleh Hooshangi 2
- Hadis Hooshangi 2
- Farhad Hooshangi 2
- Fahimeh Hooshangi 2
- Ehsan Hooshangi 2
- Danial Hooshangi 2
- Camellia Hooshangi 2
- Benyamin Hooshangi 2
- Behrooz Hooshangi 2
- Babak Hooshangi 2
- Arvin Hooshangi 2
- Arshad Hooshangi 2
- Arian Hooshangi 2
- Amin Hooshangi 2
- Ali Hooshangi 2
- Afshin Hooshangi 2
- Abbas Hooshangi 2
- Zabih Hooshangi
- Vistaa Hooshangi
- Vida Hooshangi
- Vahab Hooshangi
- Tara Hooshangi
- Tania Hooshangi
- Souri Hooshangi
- Soraya Hooshangi
- Soheila Hooshangi
- Shohreh Hooshangi
- Shirin Hooshangi
- Shahrokh Hooshangi
- Shahram Hooshangi
- Shabnam Hooshangi
- Setareh Hooshangi
- Sepideh Hooshangi
- Sasan Hooshangi
- Sakineh Hooshangi
- Saheb Hooshangi
- Saeede Hooshangi
- Rozhina Hooshangi
- Roxan Hooshangi
- Roshanak Hooshangi
- Rezvan Hooshangi
- Porteghal Hooshangi
- Poorak Hooshangi
- Pejman Hooshangi
- Pegah Hooshangi
- Parishad Hooshangi
- Parham Hooshangi
- Ormoz Hooshangi
- Nima Hooshangi
- Niloofar Hooshangi
- Neiloofar Hooshangi
- Nazanin Hooshangi
- Narges Hooshangi
- Najmeh Hooshangi
- Nafiseh Hooshangi
- Mojdeh Hooshangi
- Mohammadali Hooshangi
- Mohamad Hooshangi
- Mitra Hooshangi
- Minoo Hooshangi
- Mina Hooshangi
- Mehrdad Hooshangi
- Mehran Hooshangi
- Mazyar Hooshangi
- Masoud Hooshangi
- Masood Hooshangi
- Maryam Hooshangi
- Maliheh Hooshangi
- Mahshid Hooshangi
- Mahoo Hooshangi
- Mahnaz Hooshangi
- Mahmood Hooshangi
- Mahdieh Hooshangi
- Mahboubeh Hooshangi
- Laylia Hooshangi
- Ladan Hooshangi
- Kimia Hooshangi
- Kamo Hooshangi
- Kamal Hooshangi
- Javati Hooshangi
- Javad Hooshangi
- Jamshid Hooshangi
- Jaber Hooshangi
- Hooman Hooshangi
- Hiva Hooshangi
- Goli Hooshangi
- France Hooshangi
- Forogh Hooshangi
- Farzin Hooshangi
- Farinaz Hooshangi
- Farbod Hooshangi
- Fabod Hooshangi
- Esfandiar Hooshangi
- Elmira Hooshangi
- Donya Hooshangi
- Diar Hooshangi
- Borhan Hooshangi
- Bita Hooshangi
- Beny Hooshangi
- Behzad Hooshangi
- Barbod Hooshangi
- Bahar Hooshangi
- Badri Hooshangi
- Aslan Hooshangi
- Armin Hooshangi
- Arash Hooshangi
- Ana Hooshangi
- Alieh Hooshangi
- Alen Hooshangi
Typos & Misspells
hooshagni, hosohangi, hooshang, hooshangia, hooshsngi, hooshango, hooshangie, hooshangii, hooshangio, hooshanngiTop Images for Hooshangi